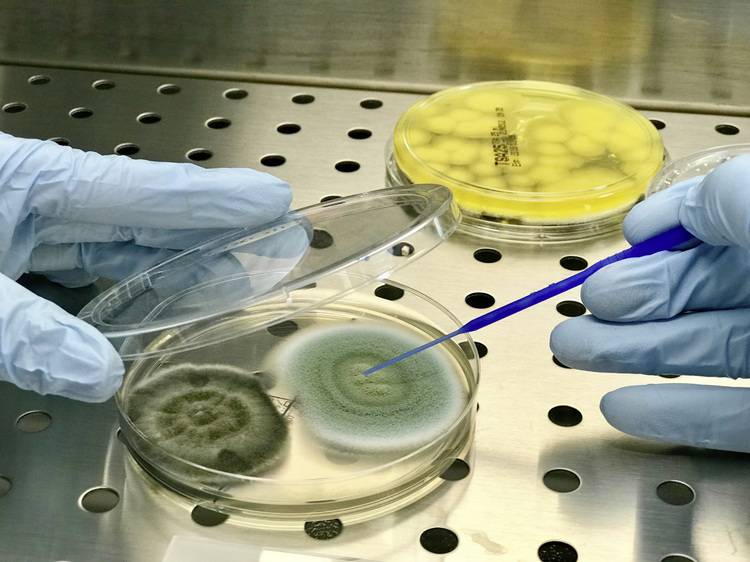

Warum Raumlufttechnik und -hygiene ganzheitlich betrachtet werden sollten
Dass RLT-Anlagen keinesfalls die alleinige Lösung sind, sondern nur unterstützend hinzugezogen werden sollten, haben diverse Expertengremien bereits bestätigt, u. a. das Umweltbundesamt, die Deutsche Gesetzliche Unfallversicherung und die Deutsche Gesellschaft für Krankenhaushygiene. [Literatur: 1][2][3] – und damit die erwähnte ganzheitliche Betrachtung. Dazu gehören im Wesentlichen drei Eckpunkte:
- qualifizierte hygienische Inspektion und Bewertung der RLT-Anlage;
- qualifizierte hygienische Behandlung der RLT-Anlage;
- Dichtigkeit von Luftleitsystemen (Lüftungskanälen).
Hygienische Inspektion und Bewertung
Es gibt verbindliche Normen und Richtlinien, welche die Hygiene in Raumlufttechnischen Anlagen regeln.
So betrifft die Richtlinie VDI 6022-2018:01 [4] alle Räume, in denen sich dieselbe Person entweder mehr als 30 Tage pro Jahr oder regelmäßig länger als 2 h pro Tag aufhält. Somit darf die VDI 6022 für den Alltagsgebrauch zurecht als eine der wichtigsten Richtlinien und Leitlinien betrachtet werden. Leider hat sich – trotz der Entfernung einiger Unschärfen – auf dem Markt ein breites Sammelsurium an Auslegungen der Richtlinie angesammelt.
Um den hygienischen Betrieb sicherzustellen, legt die VDI 6022 hierbei verschiedene Inspektionsintervalle fest – abhängig vom Betrieb der Anlage. Hierbei gilt: Anlagen ohne Befeuchter müssen alle drei Jahre inspiziert werden, Anlagen mit Befeuchter alle zwei Jahre. Sollte es aus besonderen Gründen notwendig sein (z. B. stark verschmutzte Außenluft) kann jeder Sachkundige der Kategorie A diesen Prüfzyklus auch verkürzen. Die Inspektion der Anlage besteht dann aus einer visuellen Überprüfung der Anlage, einer mikrobiologischen Untersuchung, einer konstruktiven Beurteilung sowie einer ausführlichen Dokumentation der Inspektion inklusive der Laborwerte.
Bei den mikrobiologischen Untersuchungen gilt seit Januar 2018: Augen auf! Solche Untersuchungen gelten der Bestimmung von Gesamtkoloniezahl, Legionellen, Pseudomonaden sowie Pilzen und Hefen. Damit soll festgestellt werden, in welchem Maße die RLT-Anlage mikrobiologisch kontaminiert ist und die angesaugte Außenluft negativ beeinträchtigt. Untersucht wird sowohl die durch die Anlage strömende Luft, die Vergleichsluft (z. B. Außenluft), das Umlaufwasser von Luftbefeuchteranlagen und das Rückkühlwasser.
Sorgfältige Probenahme und Bewertung
Die Probennahme hat hier mit sogenannten Dip-Slides zu erfolgen. Mittels Abklatschplatten werden Oberflächenproben entnommen. War es früher üblich, dass die Oberflächenproben ausschließlich auf Basis von Casein-Sojamehl-Pepton (CASO) Agarplatten genommen wurden, so fordert die VDI 6022 nun explizit, dass Oberflächen- und Luftkeimuntersuchungen mit Selektivnährmedien zur Auswertung von Gesamtkeimzahlen und Schimmelpilzen durchgeführt werden. Gängige Nährmedien sind hier die erwähnten CASO-Agarplatten zur Bestimmung von Bakterien oder Agars aus Malzextrakten bzw.
Dichloran Glycerol (DG-18) zur Bestimmung von Schimmelpilzen.
Die Addition der kultivierten koloniebildenden Einheiten (KBEs) beider Nährböden ergibt das Resultat des Probenpunktes, welches mit den festgelegten Grenzwerten verglichen wird. Eine obligatorische Differenzierung der Schimmelpilze in den Abklatsch- und Luftkeimproben bis auf Ebene der Art ist seit Januar 2018 verpflichtend. Ebenfalls ist die bisher optionale vergleichende Luftkeimuntersuchung verpflichtend geworden. Die Anzahl der Messstellen wird hierbei durch den Sachkundigen festgelegt.
Wichtig ist, dass diese Prüfpunkte bei den darauffolgenden Inspektionen ebenfalls verwendet werden, um eine mikrobiologische Entwicklung der Anlage zu beobachten. An schwer zugänglichen Stellen (z. B. Wärmeregister) müssen, seit Neufassung der VDI 6022, Proben mittels Abstrichen entnommen werden. Die Differenzierung der Schimmelpilze ist hier ebenfalls wieder verpflichtend.
Vor Inbetriebnahme, bei baulichen Veränderungen oder nach längerem Stillstand der Anlage ist eine Hygiene-Erstinspektion durchzuführen. Diese ist in ihrer Durchführung umfangreicher, da hier insbesondere auf die bauliche Ausführung der Anlage und deren Einfluss auf die Luftqualität eingegangen wird. Auf Basis dieser Inspektion müssen ggf. entsprechende Maßnahmen eingeleitet und umgesetzt werden. Zu beachten ist, dass auch bei sog. RLT-Kleinanlagen (Anlagen, deren einzige Aufgabe das Filtern und / oder das Erwärmen von Luft ist) eine Hygiene-Erstinspektion gemäß VDI 6022 durchgeführt werden muss. Somit fallen auch die zuvor genannten „Luftreiniger“ unter diese Richtline.
Ebenfalls ist zu beachten, dass die Messung von Schadstoffen gemäß VDI 6022 nur durch einen RLQ-Ingenieur durchgeführt werden darf.
Welche Anforderungen an Lüftungsanlagen gibt es?
Die DIN 1946-4 [5] beschreibt die Anforderungen an Lüftungsanlagen in Räumen des Gesundheitswesens. Hierunter fallen insbesondere Raumluftanlagen für Operationsräume der Klasse Ia (Räume mit turbulenzarmer Verdrängungsströmung) und der Klasse Ib (Räume mit turbulenter Verdünnungsströmung) sowie sämtliche andere Räume in Krankenhäusern.
Die DIN 1946-4 beschreibt neben den allgemeinen Anforderungen an das Lüftungsgerät und die Lüftungsleitungen (z. B. Anzahl und Klasse der Filterstufen) vor allem die Anforderungen an die Qualität in den versorgten Räumen. So wird über diese auch geregelt, wann und wie die Überprüfung der endständigen Schwebstofffilter auf Leckagen (in Verbindung mit DIN 14644-3), die Messungen des Schutzbereichs bzw. des Turbulenzgrades oder auch das mikrobiologische Monitoring hinsichtlich der Luftkeimbelastung zu erfolgen hat.
Aufgrund der verantwortungsvollen Tätigkeit müssen sämtliche Messungen im Zusammenhang mit der DIN 1946-4 durch einen erfahrenen Hygiene-Ingenieur durchgeführt und mit einem Krankenhaushygieniker beurteilt werden.
In Fachkreisen besteht schon seit mehreren Jahren die Diskussion, ob Raumluftanlagen nicht in verschiedene „Hoheitsbereiche“ unterteilt sind. Sprich: Bis wohin gilt die VDI 6022, ab wann gilt die DIN 1946-4? Eigentlich gibt es darauf eine klare Antwort.
Die DIN 1946-4 hat als rechtlich höherwertige Norm den Vorrang vor der Richtlinie VDI 6022. Jedoch beinhaltet die VDI 6022 einige wichtige Aspekte (z. B. mikrobiologische Untersuchungen im Lüftungsgerät), die auch bei Raumlufttechnischen Anlagen im Gesundheitswesen von Vorteil sein könnten. Empfehlenswert ist daher eine Inspektion der RLT-Anlage gemäß DIN 1946-4 in Verbindung mit Elementen der VDI 6022.
Besondere Anforderungen an Reinräume
Die DIN EN ISO 14644 [4] [6] regelt die Anforderungen an Reinräume und beschreibt die notwendigen Messverfahren für Abnahmequalifikation sowie für die Requalifikation eines Reinraumes. Die ISO 14644 gilt mit dem Ausgabestand 2016-06 weltweit als der aktuelle Stand der Technik und ersetzt somit zurückgezogene Normen wie den US Federal Standard 209 E. Leider muss jedoch festgestellt werden, dass viele Anbieter auf dem Markt Reinräume noch auf Basis des US Federal Standard 209 E qualifizieren, obwohl dieser seit dem Jahr 2001 zu Gunsten der DIN 14644 zurückgezogen wurde.
Die DIN 14644 beschreibt neben den Maximalwerten der verschiedenen ISO-Klassen hinsichtlich partikulärer Kontamination auch die Messerverfahren zur Überprüfung der Filterintegrität (Überprüfung der Schwebstofffilter auf Leckagen), die Anzahl der notwendigen Messpunkte zur Bestimmung der partikulären Kontamination auch Messverfahren zur Erholzeitmessung etc.
Insgesamt ist aus den Anforderungen der erwähnten Normen ersichtlich, ist das Thema Raumlufthygiene nicht so trivial ist, wie es gelegentlich dargestellt wird. Hierbei wurde insbesondere auf solche Rechtswerke Bezug genommen, die sich in ihrem Kern mit der RLT-Anlage auseinandersetzt oder deren „Endprodukt“ eine korrekte funktionierende RLT-Anlage voraussetzt. Darüber hinaus gibt es jedoch weitere Thematiken wie z. B. MAK-Werte oder BRC-Vorgaben, die ebenfalls umfassende Anforderungen beinhalten. Es zeigt sich, dass technische Verantwortliche und Dienstleister ggf. Sachkunde in verschiedenen Bereichen besitzen müssen, um die verschiedenen Anforderungen an das Gerät und die versorgten Räume zu verstehen um somit passende Lösungen zu finden.

Hygienische Behandlung der RLT-Anlage
Die Produktion von Inspektionsergebnissen und Befunden ist das eine, die richtigen Schlussfolgerungen daraus zu ziehen und diese richtig umzusetzen das andere. Während es die DIN 1946-4 oder die VDI 6022 zum Beispiel geschafft haben, ein klares Anforderungsprofil an die Beteiligten einer Hygieneinspektion zu stellen, fehlen diese Anforderungen jedoch an das Personal, welche die Anlage letztendlich einer hygienischen Behandlung unterziehen soll.
Wie wichtig ein solcher Anforderungskatalog jedoch ist, hat sich insbesondere im Zuge der SARS-CoV-2-Pandemie gezeigt. Teilweise wurden Desinfektionen von völlig unqualifiziertem Fachpersonal durchgeführt, Sprüh-Desinfektion als RKI-konformes Desinfektionsverfahren verkauft oder RLT-Anlagen mit alkoholhaltigen Reinigungsmitteln gereinigt und desinfiziert – jenseits aller Vorgaben des Arbeitsschutzes und des gesunden Menschenverstands.
Auf den Hygieneplan kommt es an

Neben den Anforderungen an das Reinigungspersonal ist ebenfalls die Vorlage eines durchdachten Hygieneplans notwendig. Die Wichtigkeit einer hygienisch funktionierenden RLT-Anlage hat gezeigt, dass ein „one size fits all“ - Reinigungs- und Hygieneplan nur schwer zum gewünschten Ergebnis führen kann. Ein solcher Plan kann nur in Zusammenarbeit mit Fachleuten erarbeitet werden, welche alle relevanten Faktoren (z. B. Umweltbedingungen, versorgte Räume, Leitungsnetz, bauliche Begebenheiten der RLT-Anlage) sowohl technisch als auch hygienisch bewerten können. Die Erstellung eines solch individualisierten Hygieneplans wird ebenfalls in der VDI 6022 gefordert.
Generell ist darauf hinzuweisen, dass eine Desinfektion ohne vorherige Reinigung nicht wirksam bzw. nur teilweise wirksam ist. Jedes Desinfektionsmittel verfügt über einen sog. Eiweißfehler. Dieser beschreibt den Grad der Wirkungsverminderung durch Proteine. Ein Eiweißfehler entsteht durch die Bindung des Desinfektionsmittels an Proteine, bevor dieses die eigentlichen Mikroorganismen erreichen kann.
Ebenfalls ist darauf hinzuweisen, dass die Scheuer-Wisch-Desinfektion das einzige anerkannte Desinfektionsverfahren des Robert-Koch-Instituts darstellt. Lediglich in besonderen Fällen (z. B. keine Zugänglichkeit für eine Scheuer-Wisch Desinfektion [7]) ist eine Sprühdesinfektion erlaubt. Somit ist es jedoch auch unbedingt notwendig, dass schwer erreichbare Teile wie zum Beispiel Lüftungskanäle vorher zumindest grob gereinigt wurden, um einen Desinfektionserfolg für den gesamten Weg des Lufttransports zu gewährleisten.
Notwendig sind also klare Anforderungen für das Dienstleistungspersonal – und daran fehlt es vielfach. Damit ist der Gesundheitsschutz gefährdet.
Dichtigkeit von Lüftungssystemen
War bisher die Dichtigkeit von Luftleitsystemen nur aus energetischen Gründen von Bedeutung und der Hygienegedanke eher stiefmütterlich betrachtet, zeigt sich nun auch, dass jedes Lüftungskonzept nur so stark ist wie sein schwächstes Glied – die Luftleitungen.
„Out of sight, out of mind“ ist leider oft die Devise bei bereits installierten Luftleitungen und Luftleitsystemen. Dabei sind gerade dichte Luftleitungen ein wichtiger Baustein für den hygienischen Betrieb einer RLT-Anlage! Bei unbekannter Luftdichtheitsklasse des Luftleitsystems (d. h. es wurde keine Dichtigkeitsprüfung bei Inbetriebnahme durchgeführt) ist mit bis zu 15 Prozent Leckage zu rechnen, bei Luftdichtheitsklasse ATC 5 (ehemals Klasse A, niedrigste Klasse) sind es immerhin noch 6 Prozent, bei der zweithöchsten Luftdichtheitsklasse ATC 3 (ehemals Klasse C, welche durch die VDI 6022 für Büro- und Verwaltungsgebäude empfohlen wird) sind es sogar nur noch 0,67 Prozent [4] [8].
Ein einfaches Rechenbeispiel verdeutlicht, welche gravierenden Auswirkungen die Luftdichtheit hat:
Eine RLT-Bestandsanlage (inkl. Luftleitungen) der Geräteklasse 2 mit Lufterwärmung aus dem Jahr 1989 soll einen Nennvolumenstrom von 10.000 m3/h fördern. Die Dichtheitsklasse wurde nicht bestimmt. Somit ist mit einer Leckluftrate von 15 Prozent zu rechnen. Dies bedeutet, dass die Anlage pro Stunde ca. 1500 m3 auf dem Weg zum Luftauslass verliert. Somit erreichen nur noch 8500 m3/h den zu versorgenden Raum, was im Endeffekt eine Verringerung des Luftwechsels bewirkt.
Nehmen wir an, dass bei einer RLT-Anlage, die auch für die Abfuhr von Abluft zuständig ist, eine gleiche Leckluftrate vorliegt, führt dies zu einer weiteren Abnahme der Anlageneffektivität und damit des Luftwechsels. Würde die besagte Anlage die geforderte Klasse ATC 3 erreichen, betrüge die Leckluftrate nur noch 0,67 Prozent. Ebenfalls zeigt sich, dass eine Volumenstromänderung von 10 Prozent eine 33 Prozent höhere Leistungsaufnahme des Ventilators bedeutet.
Neben einem verringerten Volumenstrom und dem damit verbundenen verringerten Luftwechsel muss bei undichten Luftleitungen ebenfalls damit gerechnet werden, dass Luft an Stellen austritt, an welchen ein Luftaustritt nicht erwünscht ist. Dies ist vor allem dann nachteilig, wenn Lüftungsleitungen zum Beispiel durch eine abgehängte Decke verlaufen. Oft sind Deckentypen gerade in Innenstadtbereichen mit Mäuse- und Rattenkot kontaminiert. Durch Staubpartikel werden somit etwaige Viren (z. B. Hanta-Virus) unkontrolliert und ungefiltert in Räume getragen. Ähnlich verhält es sich im Abluftbereich. Undichte Luftleitungen können auf ihrem Weg kontaminierte Luft verlieren, bevor diese die Filtereinrichtungen des Abluftgeräts erreichen.

Fazit
Die Raumlufttechnik erhält nun endlich die notwendige Aufmerksamkeit der breiten Öffentlichkeit. Wie sich jedoch zeigt, ist das Thema Raumlufthygiene und die damit verbundene Hygiene von Raumlufttechnischen Anlagen nicht gerade trivial. Verschiedene Rechtswerke, spezielle Anforderungen an die Reinigung und Instandhaltung, sowie eher noch unbekannte Parameter wie die Leckluftrate müssen zur hygienischen Evaluation einer RLT-Anlage herangezogen werden.
Im ersten Schritt ist es wichtig zu wissen, welches technische Regelwerk für den individuellen Fall gilt. Eventuell können hier verschiedene Normen und Richtlinien zur Anwendung kommen. Die Ergebnisse der Untersuchungen sollten zur Festlegung eines individuellen Hygieneplans werden. Es ist ein individuelles und durchdachtes Hygienekonzept für jede einzelne RLT-Anlage notwendig, welches die baulichen, hygienischen und betrieblichen Aspekte vollumfänglich einschließt.
Literatur und Quellen
[1] Umweltbundesamt (2020), Mobile Luftreiniger in Schulen: Nur im Ausnahmefall sinnvoll.
[2] Deutsche Gesetzliche Unfallversicherung (DGUV) (2020), Fachbeitrag der DGUV zu mobilen Raumluftreinigern zum Schutz vor SARS-CoV-2.
[3] Deutsche Gesellschaft für Krankenhaushygiene (2020), Stellungnahme der DGKH zum Einsatz von dezentralen mobilen Luftreinigungsgeräten im Rahmen der Prävention von COVID-19.
[4] Verein Deutscher Ingenieure (VDI) (2018), Richtlinie VDI 6022:2018-01 - Raumlufttechnik und Raumluftqualität.
[5] Deutsches Institut für Normung e.V. (DIN) (2018), Norm DIN 1946-4:2018-09 – Raumlufttechnische Anlagen in Gebäuden und Räumen des Gesundheitswesens.
[6] Internationale Organisation für Normung & Deutsches Institut für Normung e. V. (DIN) (2016), Norm DIN EN ISO 14644: 2016-06 – Reinräume und zugehörige Reinraumbereiche.
[7] Robert-Koch-Institut (2017), Liste der vom Robert-Koch-Institut geprüften und anerkannten Desinfektionsmittel und -verfahren.
[8] MEZ-Technik GmbH (2020), Energieeffizienz, abgerufen am 19.11.2020: mez-technik.de/de/mez-aeroseal/vorteile.html (Link nicht mehr gültig). Neuer Link: https://www.mez-technik.de/de/aeroseal/vorteile.html